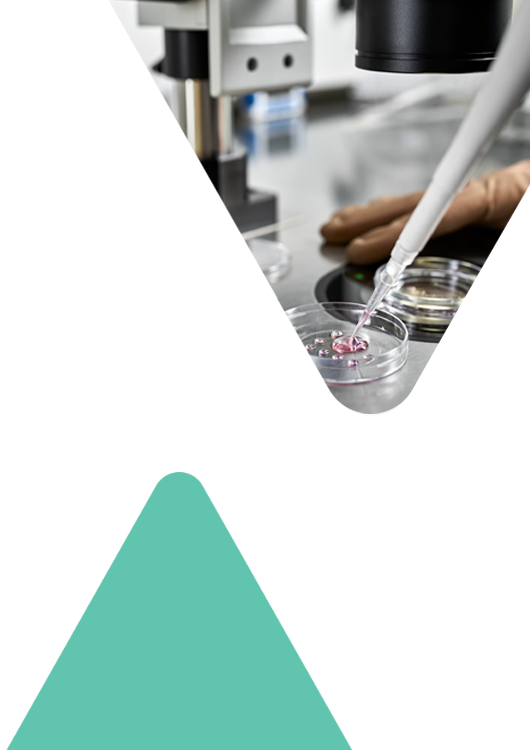

IVF/ICSI
With Sperm Donation
Treatment
In Vitro Fertilisation or Intracytoplasmic Sperm Injection with Sperm Donation
In a natural situation, the egg is fertilised by the sperm within the woman’s reproductive system. The fertilised egg then divides to form an embryo that will implant in the uterus and result in a successful pregnancy. In some cases, however, the absence of sperm or their inability to fertilise eggs or generate good-quality embryos may make a natural pregnancy impossible. In vitro fertilisation (IVF) and intracytoplasmic sperm injection (ICSI) are medically assisted reproduction (MAR) techniques that, together with sperm donation, can create embryos and achieve a desired pregnancy. In these techniques, the fertilisation of the egg by the sperm takes place in a laboratory and the embryo (or embryos) is then transferred to the mother’s uterus so that a pregnancy can occur.
IVF or ICSI with sperm donation is indicated in the following situations:
- Absence of sperm in opposite-sex couples
- Inability of sperm to fertilise or serious cases of proven poor embryo quality in previous cycles
- Failure of intrauterine insemination with donated sperm
- Treatment of women without a male partner
- Treatment of female same-sex couples
In Vitro Fertilisation or Intracytoplasmic Sperm Injection with Sperm Donation
Your Treatment Step By Step
1 - Tests and Exams
One of the first steps is to perform tests and exams. Your physician needs them to assess your clinical status. These may include a gynaecological ultrasound, hormone tests or infectious disease screening. After assessing them, your physician will decide which treatment is most appropriate to your diagnosis.
Before you go ahead with treatment with donated sperm, you will be asked to attend a psychological counselling appointment at our clinic (with your partner, if applicable). Although it is compulsory, it is just a counselling session to discuss the legal, emotional and social implications of this type of treatment.
2 - Sperm Donor Collection
In this phase of your treatment, you will be contacted by a member of our team of embryologists for the selection of the most appropriate sperm donor for your treatment. In addition to its own sperm bank, AVA Clinic also has agreements with international sperm banks that meet all the quality and safety standards required by our own National Medically Assisted Procreation Council (CNPMA). This offers a wide range of possibilities for anyone wishing to use donated sperm.
After the sperm donor has been selected we will be able to start your treatment at any time suitable to you. If you undergo IVF or ICSI with donated sperm, there will be a four-to-five-week period between the start of treatment and your pregnancy test.
3 - Ovarian Stimulation
The treatment begins with ovarian stimulation to make your ovaries produce more than one egg. Without medication, a woman’s ovary releases one egg in each cycle. In IVF or ICSI, the ideal is for us to be able to retrieve several eggs in the same cycle so that more embryos can be created in the lab. This is why stimulation is necessary.
Your ovaries will be stimulated with hormone injections. There are different protocols for ovarian stimulation and your physician will decide which one is best for you.
During this phase (lasting an average of 10 days) we will need you to visit our clinic two or three times so that the growth of your follicles (small sacs where your eggs grow) can be monitored by ultrasound. Your protocol may be adjusted at any time and your hormone dosages may be changed. This ultrasound monitoring is therefore essential to the success of your treatment.
4 - Egg Collection
As soon as your follicles reach the ideal size, we will schedule your egg collection. This procedure is performed in an operating theatre under anaesthesia and is therefore not painful.
The retrieved eggs are then taken to the lab where they will be stored under conditions similar to those of the human body. These conditions are perfect for fertilisation and subsequent development of the resulting embryos.
It will not take you more than around three hours to recover from the procedure on the day of your egg collection and you can go back to your daily routine as soon as you leave the clinic (with any exceptions indicated by your physician).
5 - Sperm Thawing
On the same day as the egg collection, we will thaw the selected donor’s sperm so that your eggs can be joined with it. After assessing the thawed sperm, our embryologists will use lab techniques to select the ones with the best motility and morphology. There are a number of techniques to improve sperm samples and our embryologists will make sure that they choose the most appropriate one for each case.
6 - Egg Fertilisation
The eggs will be inseminated with the selected sperm in the lab on the same day of your egg collection. We will use one of two techniques to fertilise your eggs:
-
In vitro fertilisation (IVF)
In this technique, we simply put your eggs together with the right quantity of selected sperm so that fertilisation can take place. This is the classic, physiologically most natural fertilisation method as it involves little handling of your cells. The sperm will be responsible for finding and penetrating the eggs to fertilise them.
-
Intracytoplasmic sperm injection (ICSI)
In certain cases in which it is not possible to perform IVF, the chosen technique is ICSI. One sperm per egg is selected and injected into it. We use special, high-precision equipment (microscopes, microinjectors and microneedles) for this procedure to ensure that we achieve good fertilisation rates.
ICSI is the technique of choice in cases in which we suspect or have confirmed that fertilisation is not possible (or has produced poor results) with IVF.
The choice of technique for your treatment will be made on the basis of a number of criteria to ensure the best possible results. The fertilisation rates are similar for both techniques but neither of them guarantees fertilisation of 100% of your eggs.
7 - Embryo Culture
The day after your eggs have been retrieved, our team of embryologists will contact you with news about your treatment. This is when you will find out how many embryos will be developing over the next few days. During this culture period, which may vary from two to five days, your embryos will be safe in our lab and our embryologists will ensure that they have the ideal conditions for their development.
The embryologists will decide on the best day to schedule the transfer of your embryos to the uterus. This decision will depend not only on the quantity but also the quality of the embryos. The embryologists will conduct a careful assessment of each embryo every day to ensure that the best ones are chosen on the day of your embryo transfer.
While your embryos are being cultured in the lab, your doctor will prescribe you medication to help prepare your uterus to receive the embryos. It is important for you to keep taking this medication until your physician or one of our nurses tells you otherwise.
8 - Embryo Transfer
On the day of your embryo transfer, our embryologists will inform you on how many good-quality developing embryos you have. If there are more good-quality embryos than you want to transfer, our lab team will cryopreserve them for future use (vitrification method). Cryopreserved embryos remain intact and at the same stage of development until they are thawed. Around 95% of embryos are totally unaffected by this freezing and thawing process.
At AVA Clinic you will be given the choice of transferring one or two embryos. However, we will probably advise you on the ideal number to transfer in order to achieve a healthy pregnancy and delivery.
The transfer procedure is performed in the operating theatre. No anaesthesia is needed in this case, as it is practically pain-free, much like a gynaecological examination. The embryos are transferred to your uterus via the cervix by means of a very thin catheter. With the aid of an ultrasound probe, your embryos are placed directly in the place where they should implant to result in a pregnancy.
9 - Pregnancy Test
Today’s the day! After what we know is a difficult wait, it’s time to do the long-awaited pregnancy test. The test is normally conducted about two weeks after your egg collection. You will have to take a blood test to confirm your pregnancy. You can take the test in the comfort of our clinic though, if this is not convenient, you can do it at any lab testing facility.
The AVA Clinic team wishes you the best of luck with your treatment. And don’t forget that you can contact us at any time if you have any questions.
Get in touch
Submit the form to get in touch with one of team to discuss your questions about IVF/ICSI with Sperm Donation.